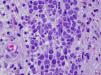

Varón de 55 años con antecedentes personales de neurofibromatosis tipo 1, feocromocitoma suprarrenal, hipotiroidismo primario en tratamiento sustitutivo con levotiroxina y leucemia mielo-monocítica crónica diagnosticada en 2005 en tratamiento actual con azacitidina. El paciente consulta por una lesión cutánea asintomática de rápido crecimiento en la zona pretibial derecha de 2 meses de evolución.
Exploración físicaPresentaba en región pretibial derecha una úlcera no supurativa de varios centímetros de diámetro, con tejido de granulación y membrana amarillenta central con aspecto purpúrico en el borde (fig. 1).
HistopatologíaLa biopsia cutánea realizada mostró la existencia de un infiltrado monomorfo de células de gran tamaño, con abundante citoplasma eosinófilo y núcleo prominente (figs. 2 y 3). El cultivo de la biopsia fue positivo para Pseudomona aeruginosa y Staphylococcus aureus meticilin resistente.
¿Cuál es su diagnóstico?
DiagnósticoInfiltración cutánea por leucemia mielo-monocítica crónica (leucemia cutis).
Evolución y tratamientoLa lesión continuó creciendo rápidamente, con afectación muscular y ósea, por lo que se remitió al paciente a hematología para tratamiento quimioterápico paliativo con citarabina y azacitidina. A pesar de todo ello la enfermedad progresó y el paciente falleció dos meses después.
ComentarioLa leucemia cutis es un término inespecífico para designar la infiltración cutánea por cualquier tipo de leucemia (mieloide o linfoide)1. Cuando se trata de precursores granulocíticos se denomina sarcoma mieloide, leucemia primaria extramedular o cloromas, mientras que si se compone de precursores monocíticos se designa bajo el término de sarcoma monoblástico. Suele darse en pacientes en los que existe afectación sistémica, aunque existen formas aleucémicas (< 10%) en las que la afectación cutánea precede a la afectación de médula ósea o sangre periférica.
Se ha descrito en pacientes con leucemia mieloide aguda (LMA), trastornos mieloproliferativos crónicos, así como en trastornos linfoproliferativos. Sucede de forma más frecuente en la LMA (10-15%), pudiendo aparecer hasta en el 50% de los subtipos monocíticos o mielo-monocíticos2,3. En las formas crónicas es menos frecuente, cuando aparece indica transformación blástica y por lo tanto progresión de la enfermedad. Es más frecuente en niños, pudiendo aparecer hasta en el 25-30% de las leucemias congénitas4.
La forma de presentación es inespecífica e incluye lesiones únicas o múltiples, en forma de pápulas, placas o nódulos violáceos de tamaño variable, localizados preferentemente en extremidades inferiores, cabeza y cuello. Menos frecuente es la presentación como petequias en la mucosa oral, infiltración de las encías5, fascies leonina, lesiones eczematosas, úlceras genitales y paniculitis simulando eritema nodoso6. En niños es una de las causas de síndrome del «niño en bollito de arándanos»4.
En los pacientes con leucemia, las manifestaciones cutáneas más frecuentes son las leucémides o afectación cutánea no leucémica, que pueden aparecer en alrededor del 40% de los pacientes. Estas lesiones cutáneas aparecen como resultado de citopenias o reacciones a fármacos. Suelen presentarse como petequias, púrpuras, equimosis, vasculitis leucocitoclástica, dermatosis neutrofílica e infecciones oportunistas.
El diagnóstico diferencial clínico de la leucemia cutis debemos realizarlo con infecciones cutáneas en el contexto de pacientes inmunodeprimidos, metástasis de tumores no linfoides, infiltrado linfocitario de Jessner y tumores anexiales. El diagnóstico definitivo se establece en base a los hallazgos histológicos1.
En la histología podemos encontrar un infiltrado perivascular y perianexial, o un infiltrado denso difuso intersticial, que respeta la epidermis, que en el caso de la leucemia mieloide está compuesto de células de gran tamaño, amplio citoplasma eosinofílico, gran núcleo y pequeño nucléolo. Pueden encontrarse figuras mitóticas abundantes. La infiltración neural, anexial y muscular es infrecuente.
La leucemia cutis es una manifestación local de la enfermedad de base, por lo tanto, el tratamiento debe estar encaminado a erradicar la enfermedad subyacente. Entre las opciones disponibles encontramos la quimioterapia sistémica y el tratamiento específico de la leucemia cutis mediante extirpación quirúrgica, PUVA, mostaza nitrogenada tópica y dacluzimab6. El pronóstico es infausto, la enfermedad sigue un curso agresivo y la tasa de supervivencia es baja (< 10% en 1 año).
Conflicto de interesesLos autores declaran que no tienen ningún conflicto de intereses.